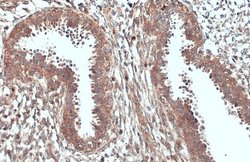
Invitrogen ACSL3 Polyclonal Antibody 100 &mu;L; Unconjugated:Antibodies,

missing translation for 'onlineSavingsMsg'
Learn More
Learn More
Invitrogen™ ACSL3 Polyclonal Antibody


Rabbit Polyclonal Antibody
Brand: Invitrogen™ PA529507
This item is not returnable.
View return policy
Description
Recommended positive controls: 293T, A431, Jurkat, Raji. Predicted reactivity: Mouse (95%), Rat (95%), Pig (95%), Bovine (96%). Store product as a concentrated solution. Centrifuge briefly prior to opening the vial.
An initial reaction in fatty acid metabolism in eukaryotic cells is activation of fatty acids catalyzed by acyl-CoA synthetase. FACL3 (fatty acid CoA ligase, long-chain 3) is identified as member of the acyl-CoA synthetase (ACS) family by PCR of rat brain cDNAs using primers based on the conserved region of the ACS protein. The 720-amino acid rat protein preferentially utilizes myristate, laurate, arachidonate, and eicosapentaenoate, and is expressed primarily in brain. The predicted 720-amino acid FACL3 human protein is 92% identical to that of rat.
Specifications
| ACSL3 | |
| Polyclonal | |
| Unconjugated | |
| ACSL3 | |
| 2610510B12Rik; Acs3; Acsl3; acyl-CoA synthetase long chain family member 3; acyl-CoA synthetase long-chain family member 3; Arachidonate--CoA ligase; Brain acyl-CoA synthetase II; C85929; FACL3; fatty acid Coenzyme A ligase, long chain 3; fatty-acid-Coenzyme A ligase, long-chain 3; LACS 3; LACS3; lignoceroyl-CoA synthase; long-chain acyl-CoA synthetase 3; Long-chain-fatty-acid--CoA ligase 3; Pro2194 | |
| Rabbit | |
| Antigen affinity chromatography | |
| RUO | |
| 2181 | |
| Store at 4°C short term. For long term storage, store at -20°C, avoiding freeze/thaw cycles. | |
| Liquid |
| Immunohistochemistry (Paraffin), Western Blot, Immunocytochemistry | |
| 0.81 mg/mL | |
| PBS with 20% glycerol and 0.025% ProClin 300; pH 7 | |
| O95573 | |
| ACSL3 | |
| Recombinant protein encompassing a sequence within the center region of human ACSL3. The exact sequence is proprietary. | |
| 100 μL | |
| Primary | |
| Human | |
| Antibody | |
| IgG |
Product Content Correction
Your input is important to us. Please complete this form to provide feedback related to the content on this product.
Product Title
Spot an opportunity for improvement?Share a Content Correction